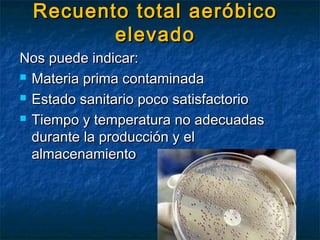
Recuento total aeróbicoRecuento total aeróbico
elevadoelevado
Nos puede indicar:Nos puede indicar:
 Materia prima contaminadaMateria prima contaminada
 Estado sanitario poco satisfactorioEstado sanitario poco satisfactorio
 Tiempo y temperatura no adecuadasTiempo y temperatura no adecuadas
durante la producción y eldurante la producción y el
almacenamientoalmacenamiento
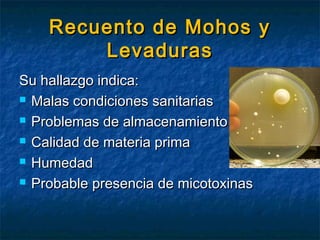
Recuento de Mohos yRecuento de Mohos y
LevadurasLevaduras
Su hallazgo indica:Su hallazgo indica:
 Malas condiciones sanitariasMalas condiciones sanitarias
 Problemas de almacenamientoProblemas de almacenamiento
 Calidad de materia primaCalidad de materia prima
 HumedadHumedad
 Probable presencia de micotoxinasProbable presencia de micotoxinas

Este documento describe diferentes tipos de microorganismos que se encuentran en los alimentos y su clasificación. Explica indicadores microbiológicos como recuentos de bacterias aeróbicas y coliformes que indican la calidad de los alimentos. También describe patógenos comunes como Salmonella, E. coli y Listeria que causan enfermedades transmitidas por los alimentos. Finalmente, detalla factores como síntomas, períodos de incubación y alimentos implicados para diferentes patógenos bacterianos.